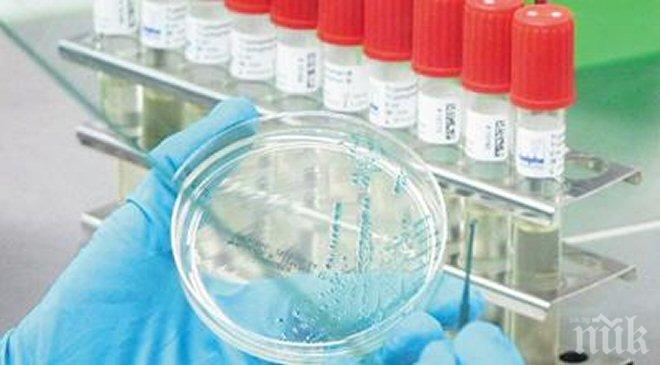
Епидемичен взрив от COVID-19 на кораб с филипинци на пристанище Бургас

ПИК с нов канал в Телеграм
Последвайте ни в Google News Showcase
Епидемичен взрив от COVID-19 на кораб на пристанище Бургас констатираха здравните власти. Първият заболял е с оплаквания от 7 юли – отпадналост, кашлица, температура. На 14 юли лицето е транспортирано до УМБАЛ Бургас за изследване и преглед, като му е направен бърз антигенен тест за COVID-19, който е с положителен резултат. Той е хоспитализиран в инфекциозно отделение на лечебното заведение. На 15 юли е организирано пробонабиране на останалите 19 лица от екипажа на кораба с PCR-тестове. 11 лица от персонала са с положителен резултат. Издадени са предписания за изолация на същите на кораба за срок от 14 дни. Общото им състояние се проследява ежедневно. Три от положителните случаи са с температура и кашлица. Контактните лица от екипажа са без оплаквания. На 18 юли хоспитализираното лице от екипажа е приведено в ОАИЛ на УМБАЛ Бургас, като на следващия ден е починало. На 19 юли друго лице от екипажа с положителен резултат за COVID-19 е със затруднено дишане и влошено общо състояние. След преглед от екип на ЦСМП Бургас е хоспитализирано в УМБАЛ Бургас.
В издаденото предписание за поставяне на екипажа под карантина РЗИ Бургас е разпоредила извършването на дезинфекция на всички помещения. Случаят се отнася за товарен кораб с екипаж от филипински граждани. Корабът пристига на пристанище Бургас на 14 юли и трябва да отпътува на 23 юли. Последното пристанище преди акостиране в Бургас е ОАЕ, на 27 юни. На 7-8 юли корабът преминава Суецкия канал, което налага качване на пилот на кораба. Екипажът се състои от 20 души. Той не се допуска до брега.
Здравните власти следят развитието на противоепидемичната обстановка и оказват стриктен контрол за недопускане разпространението на епидемията от COVID-19.